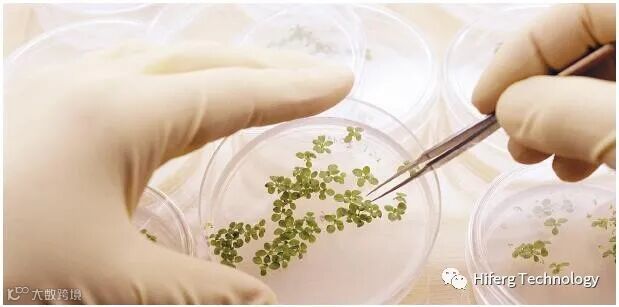

先正达是世界领先的农业公司,总部位于瑞士巴塞尔,通过帮助广大农民更有效率地使用现有资源、以提升全球的粮食安全。遍布全球90多个国家,致力于改进作物种植方法,拯救濒临退化的耕地,提高生物多样性并繁荣农村社区。
创新,尤其是研发,是先正达战略的核心。先正达在全球拥有5000多名研发人员,与大学、研究机构和商业组织建立了500多项研发合作,凭借对植物的深入理解,广泛的技术实力以及全球覆盖,先正达能够为种植者提供整合解决方案,帮助他们可持续地提高农业生产力;同时,持续满足法规制定者、作物加工者和消费者的更高望。
近日,先正达南通技术中心引进芬兰Pixact公司的PCM结晶监测系统,此次新设备引进将促进先正达为全球的种植者提供定制化、规模化的整合解决方案,以满足其多样化的需求。

PCM结晶监测系统采用透射光原理设计,由仪器探头末端发出的激光透过测试样品,由探头另一端的高分辨率CCD相机接收透射光并对晶体成像。对于微小晶体也可以清晰成像,并保证图像质量。PCM结晶监测系统利用功能强大的图像算法,可以得到高准确度的晶体尺寸、晶体尺寸分布、晶体尺寸变化趋势、晶体形态、晶体径长比、晶体生长速率等数据。


PCM结晶监测系统不需要离线取样,可以实时监测晶型转变过程。测试过程清晰直观,既大大提高了晶型转变的研究效率和准确性,又可以避免传统显微镜的多晶型研究的取样问题、以及取样后由于条件变化导致的样品变化问题,可帮助用户优化与控制工艺流程,以及排除故障。
芬兰Pixact公司除了PCM结晶监测系统,还有PPM颗粒监测系统、PDM液滴监测系统、PBM微气泡监测系统等。

PPM颗粒监测系统是为在线分析不同形态颗粒而设计,广泛应用于微颗粒、颗粒、纤维、团块、絮状物等。
 PDM液滴监测系统是为在线分析液滴和乳液而设计。
PDM液滴监测系统是为在线分析液滴和乳液而设计。

PBM微气泡监测系统是为在线分析气泡悬浮液和泡沫体系而设计,可以得到:气泡尺寸分布、平均气泡尺寸、标准偏差、索特平均直径和累积分布参数(D10、D50、D90等)。


芬兰Pixact公司的所有在线监测系统都可以提供PIXSCOPE探头、PIXSCOPE FL非接触式探头、PIXCELL流通管,均可以应用于研发、实验室小试、千吨级中试和万吨级工业化现场。
创新是企业兴旺的灵魂,先正达与时俱进,不断推动理念创新,管理创新,科技创新,此次与北京海菲尔格科技有限公司合作,引进世界先进设备武装科研,必将实现农业生产力全球性的飞跃。


